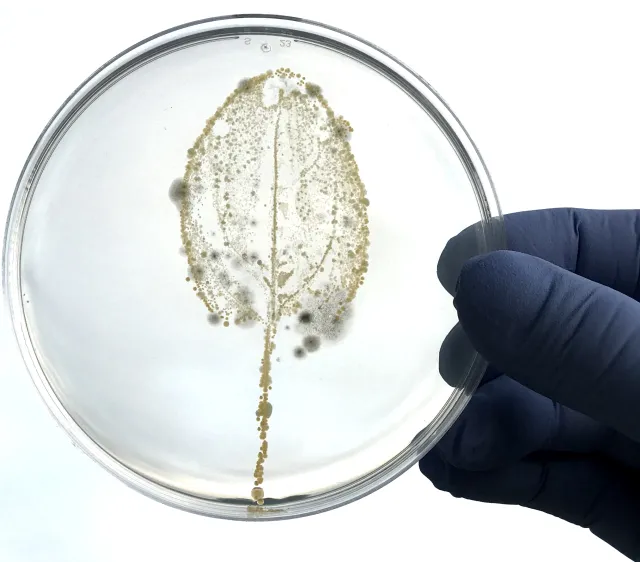

Food Safety for Small Farms
![]() Spinach leaf print on agar showing the microbes on a leaf surface
| ![]() Green labeled E. coli on the stomata opening of a spinach leaf |
Foodborne illness is common, costly, and preventable. Whether your farm is 2 acres or 2,000 acres, good agricultural practices (GAPs) and compliance with food safety regulations are important to avoid outbreaks and access markets. CDC estimates that each year 1 in 6 Americans (roughly 48 million people) get sick from contaminated food or beverages and 3,000 die from foodborne illness. The USDA estimates that foodborne illnesses cost the United States more than $15.6 billion each year.
We provide education, outreach, and technical assistance for food safety on small-scale farms with our education program on Good Agricultural Practices (GAPs), and on the Food Safety Modernization Act Produce Safety rule.We are available to help small-scale farms with food safety compliance. If you have any questions, please contact our office by calling (###) ###-#### or email us at hkdoan@ucanr.edu
Food Safety Modernization Act (FSMA) Rules and Updates
Below you will find the text of the FSMA rule. National Sustainable Agriculture Coalition (NSAC) has made more simplified versions available for both Produce Farms and Food Facilities. To see if your farm is affected by the new FSMA rule, please refer to this flow chart prepared by the NSAC.
Full Text of the Food Safety Modernization Act (FSMA)
NSAC's Simplified Version for Produce Farms
NSAC's Simplified Version for Food Facilities
Record-Keeping Templates
The food safety resources and downloadable templates on this site are available to print for use.
Administrative:
Employee Training Log English Espanol Hmoob Chinese
Injury Log English Espanol Chinese
Visitor Sign-In Log English Espanol Chinese
First-aid Kit Requirements (OSHA) English
First-Aid Kit Log English Espanol Chinese
Sales Log English Espanol Hmoob Chinese
Employee Break Area Log English Espanol Chinese
Hand-Wash & Restroom Cleaning Checklist English Espanol Chinese
Production:
Chemical Spray Log English Espanol Chinese
Irrigation Log English Espanol Chinese
Water Testing Log English Espanol Chinese
Water Treatment Log English Espanol Chinese
Cleaning & Sanitizing Log English Espanol Hmoob Chinese
Soil Amendment Log English Espanol Chinese
Compost Log English Espanol Chinese
Pre-Harvest Checklist English Espanol Chinese
Harvest Log English Espanol Chinese
Post-Harvest Wash Water Log English Espanol Chinese
Cold Storage Log English Espanol Chinese
Transportation Truck Inspection Log English Espanol Chinese
Wildlife & Pest Management Log English Espanol Chinese
Other resources
• Food Safety News and Update
• UC Small Farm Program Food Safety
• National Good Agricultural Practices Program
• Good Agricultural Practice Harmonization Initiative
USDA LINKS
• USDA Audit Checklist
• USDA Audit Score Sheet
• United Fresh Harmonized GAP Standards
• Produce GAPs Harmonized Checklist Pre-Farmgate
• Produce GAPs Harmonized Checklist Packing House